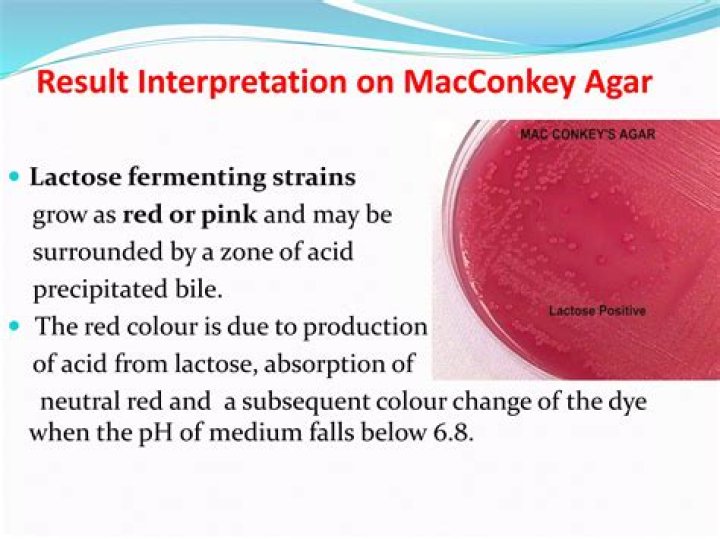

Loses color like old paint
General knowledge plays a crucial role in solving crosswords, especially the Loses color like old paint crossword clue which has appeared on June 15 2020 Crosswords with Friends puzzle. The answer we have shared for Loses color like old paint has a total of 5 letters but also has other possible answers listed below the main one. Clues often reference historical events, famous personalities, geographical locations, scientific terms, and popular culture. This makes crosswords not just a test of one's linguistic abilities but also an exercise in general knowledge and cultural literacy.
 Verified Answer
Verified Answer
Listed here below we have the other possible answers to Loses color like old paint crossword clue.
| Rank | Answer | Clue | Publisher |
|---|---|---|---|
| 99% | FADES | Loses color like old paint | Crosswords with Friends |
Recent Usage in Crossword Puzzles:
- Crosswords with Friends, June 15 2020
The most accurate solution to Loses color like old paint crossword clue is FADES
There are a total of 5 letters in Loses color like old paint crossword clue
The Loses color like old paint crossword clue based on our database appeared on June 15 2020 Crosswords with Friends puzzle



